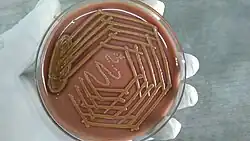

Sphingobacteriaceae
| Sphingobacteriaceae | |
|---|---|
| |
| Sphingobacterium mizutii colony | |
| Scientific classification | |
| Domain: | Bacteria |
| Kingdom: | Pseudomonadati |
| Phylum: | Bacteroidota |
| Class: | Sphingobacteriia |
| Order: | Sphingobacteriales |
| Family: | Sphingobacteriaceae Steyn et al. 1998[1] |
| Genera[2] | |
| |
Sphingobacteriaceae is a family of environmental bacteria.[1][2][3]
Phylogeny
The currently accepted taxonomy is based on the List of Prokaryotic names with Standing in Nomenclature[2] and the phylogeny is based on whole-genome sequences.[4][a]
| |||||||||||||||||||||||||||||||||||||||||||||||||||||||
Notes
- ↑ Anseongella, Nubsella, Pararcticibacter, and Pelobium are not included in this phylogenetic tree.
References
- 1 2 Steyn PL, Segers P, Vancanneyt M, Sandra P, Kersters K, Joubert JJ. (1998). "Classification of heparinolytic bacteria into a new genus, Pedobacter, comprising four species: Pedobacter heparinus comb. nov., Pedobacter piscium comb. nov., Pedobacter africanus sp. nov. and Pedobacter saltans sp. nov. proposal of the family Sphingobacteriaceae fam. nov". Int J Syst Bacteriol. 48 (1): 165–177. doi:10.1099/00207713-48-1-165. PMID 9542086.
- 1 2 3 Euzéby JP, Parte AC. "Sphingobacteriaceae". List of Prokaryotic names with Standing in Nomenclature (LPSN). Retrieved June 30, 2021.
- ↑ Boone DR, Castenholz RW, eds. (2001). Bergey's Manual of Systematic Bacteriology. Vol. 1 (The Archaea and the deeply branching and phototrophic Bacteria) (2nd ed.). New York, NY: Springer-Verlag. pp. 465–466.
- ↑ García-López M, Meier-Kolthoff JP, Tindall BJ, Gronow S, Woyke T, Kyrpides NC, Hahnke RL, Göker M (2019). "Analysis of 1,000 Type-Strain Genomes Improves Taxonomic Classification of Bacteroidetes". Front Microbiol. 10: 2083. doi:10.3389/fmicb.2019.02083. PMC 6767994. PMID 31608019.